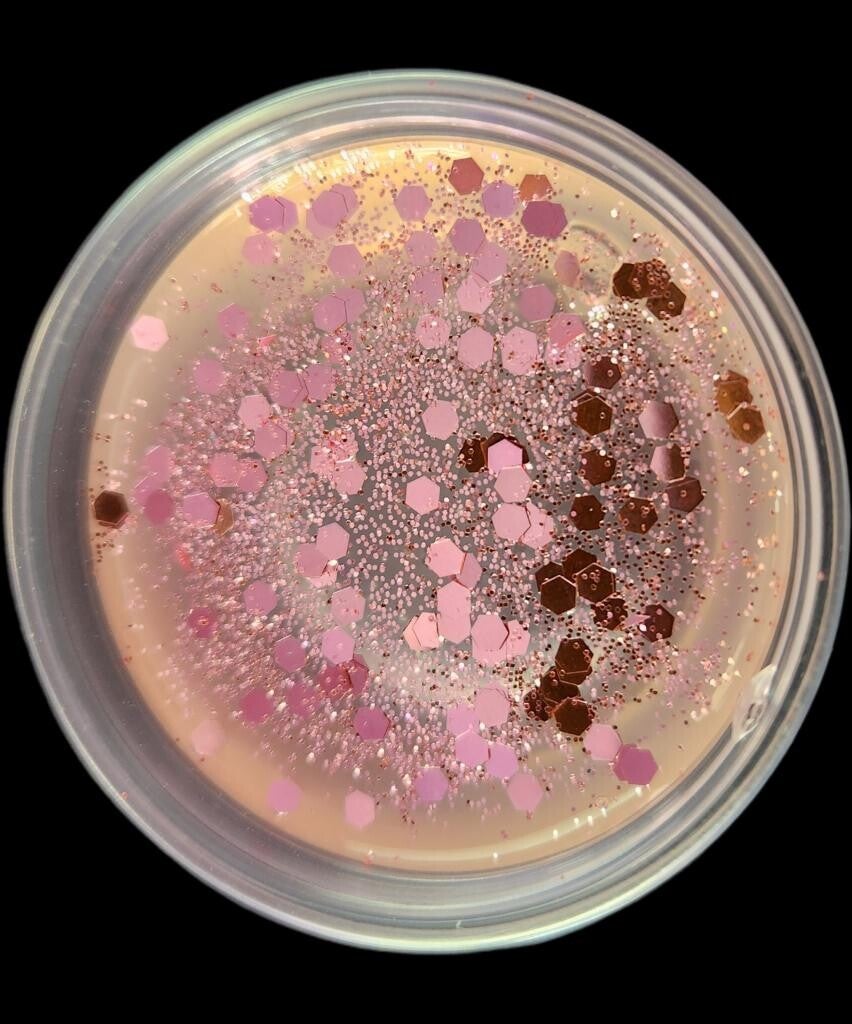
Jelly Fondant "BARBE A PAPA"
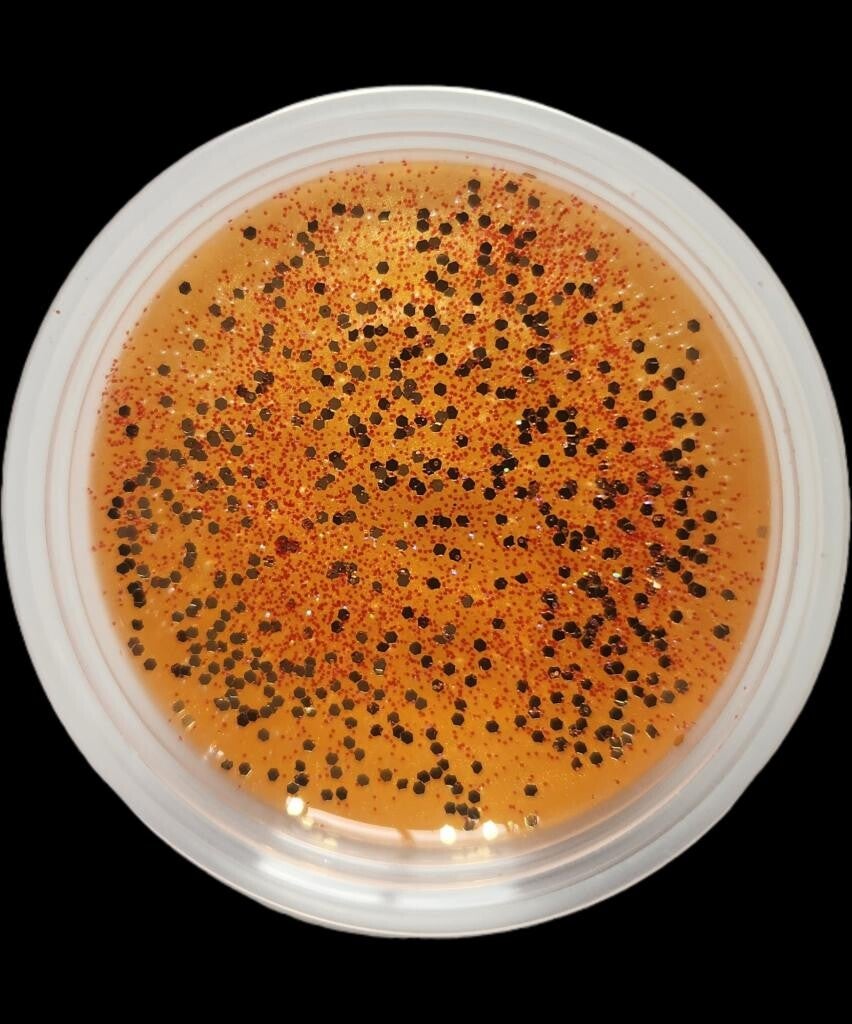
Jelly Fondant "HOTEL DE LUXE"

-
-
-
FONDANT PARFUMÉ CHOCO-BUENO 4,00 €
-
FONDANT PARFUMÉ LINGE FRAIS 4,00 €
-
FONDANT PARFUMÉ MONOÏ 4,00 €
-
FONDANT PARFUMÉ PAIN D'ÉPICE 4,00 €
-
FONDANT PARFUMÉ SAPIN 4,00 €
-
FONDANT PARFUMÉ JASMIN 4,00 €
-
FONDANT PARFUMÉ CARAMEL 4,00 €
-
FONDANT PARFUMÉ CHAMPAGNE 4,00 €
-
FONDANT PARFUMÉ COCO 4,00 €
-
FONDANT PARFUMÉ FRAISE 4,00 €
-
FONDANT PARFUMÉ BARBE À PAPA 4,00 €
-
FONDANT PARFUMÉ POMME VERTE 4,00 €
-
FONDANT PARFUMÉ PAQUES 4,00 €
-
FONDANT PARFUMÉ NUSTY GARÇON 4,00 €
-
FONDANT PARFUMÉ NUSTY FILLE 4,00 €
-
FONDANT PARFUMÉ LICORNE 4,00 €
-
FONDANT PARFUMÉ "RÉGLISSE" 4,00 €
-
FONDANT PARFUMÉ CANNELLE 4,00 €
-
FONDANT PARFUMÉ VIN CHAUD 4,00 €
-
-
Fondants Parfumés "Baie Givrée" 10,00 €
-
-
TABLETTE FONDANT PARFUMÉ MONOÏ 12,99 €
-
TABLETTE FONDANT LINGE FRAIS 12,99 €
-
COFFRET "6 FONDANTS" 20,00 €
24,00 €
-
Fondant parfumé Cannelle 4,00 €
-
Fondant parfumé Madeleine 4,00 €
-
-
Fondant parfumé Sapin 4,00 €
-
Calendrier de l’Avent – Fondants Parfumés & Bougie Cadeau Magique 40,00 €
120,00 €
-
Jelly Fondant "BARBE A PAPA" 5,00 €
-
Jelly Fondant "BEBE" 5,00 €
-
Jelly Fondant "Cerise" 5,00 €
-
-
Jelly Fondant "Linge Frais" 5,00 €
-
Jelly Fondant "Monoï" 5,00 €
-
Jelly Fondant "MUGUET" 5,00 €
-
Jelly Fondant Champagne 5,00 €
-
Jelly Fondant "Pain d'épice" 5,00 €
-
Jelly Fondant "Sapin" 5,00 €
-
Jelly Fondant "Vin Chaud" 5,00 €
-
Jelly Fondant "JASMIN" 5,00 €
-
jelly fondant Baies Givrées 5,00 €
-
jelly fondant Fleur de Noël 5,00 €
-
jelly fondant Sucre d’Orge 5,00 €
-
Jelly Fondant Bûche de Noël 5,00 €